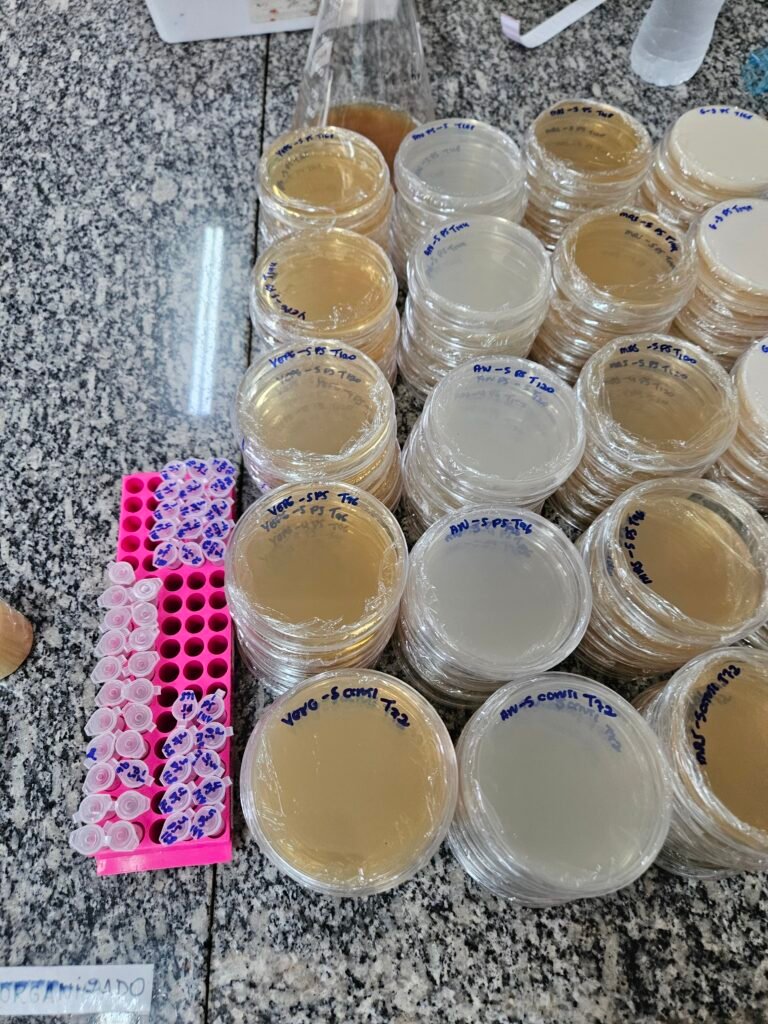

E mais: que essa transformação passaria pelos laboratórios da Universidade Federal de Lavras (UFLA).
Liderada por uma das maiores referências mundiais em fermentações, a pesquisa coordenada pela professora Rosane Freitas Schwan está usando ciência, inovação e conhecimento acumulado ao longo de décadas para transformar um cultivo ainda recente em Minas Gerais em base para a produção de cacau de qualidade — e, no futuro, de um chocolate cada vez melhor.
Desenvolvido na UFLA, o projeto conta com financiamento da FAPEMIG (Fundação de Amparo à Pesquisa do Estado de Minas Gerais) e gerenciamento da FUNDECC (Fundação de Desenvolvimento Científico e Cultural). A proposta é clara: entender o cacau desde o início, começando pela fermentação — etapa decisiva para o sabor, o aroma e a identidade do chocolate.
O sabor começa antes da barra
Ao contrário do que muita gente imagina, o chocolate não nasce doce — nem pronto. Ele começa no fruto do cacau, mais especificamente na fermentação das amêndoas, um processo conduzido por micro-organismos que transformam açúcar em sabor.
“A fermentação é indispensável. Sem ela, o cacau não tem sabor de chocolate”, explica a professora Rosane Schwan. “O que fazemos aqui é conduzir esse processo com ciência.”
Esse conhecimento não surgiu agora. Rosane dedica quase 40 anos ao estudo das fermentações e é reconhecida internacionalmente por sua atuação na área de microbiologia de alimentos. Ao longo da carreira, construiu uma coleção de micro-organismos registrada em bases nacionais e internacionais, considerada um verdadeiro legado científico. São culturas preservadas para uso atual e futuro, capazes de melhorar a qualidade de alimentos por décadas.
Quando a ciência encontra o Norte de Minas
A entrada do cacau no Norte de Minas é relativamente recente, mas vem ganhando força com apoio da pesquisa científica. A região passou a apostar na cultura do cacau em consórcio com a banana, aproveitando características do território e abrindo novas possibilidades para produtores rurais.
Enquanto o cultivo avança no campo, a ciência trabalha para entender quais micro-organismos estão presentes na fermentação do cacau produzido na região e como eles interferem no sabor do chocolate.
A doutoranda Dara Elisabete Barboza Rodrigues, da Universidade Estadual de Montes Claros (Unimontes), atua diretamente nessa etapa do estudo.
“A gente estuda os micro-organismos da fermentação do cacau do Norte de Minas para identificar quais estão ali e comparar com regiões tradicionais, como Bahia e Pará. A ideia é entender se essa microbiota influencia diretamente o sabor do chocolate.”
Do microscópio ao paladar
No laboratório, o trabalho envolve isolar micro-organismos, selecionar leveduras, acompanhar fermentações e, depois, analisar o chocolate produzido. Parte dessa análise é química — parte é sensorial.
A pesquisadora Nádia Batista atua na identificação dos compostos voláteis, responsáveis pelos aromas do chocolate, por meio da cromatografia gasosa.
“A gente consegue identificar os compostos químicos que dão aroma e sabor ao chocolate e relacionar isso com o processo de fermentação. É assim que a ciência explica o que o paladar sente.”
Esse trabalho se completa com a atuação da pós-doutoranda Ana Paula Bressane, que faz a ponte entre os dados laboratoriais e a percepção humana do sabor.
“A gente combina a análise química com a análise sensorial para entender o sabor do chocolate. A cromatografia mostra quais compostos estão ali, e a análise sensorial ajuda a compreender como isso é percebido pelas pessoas. Dependendo do objetivo, trabalhamos com consumidores ou com provadores treinados. Essa relação entre química e sensorial é fundamental para avaliar a qualidade do chocolate.”
Já a doutoranda Sandy Dias, do Programa de Ciência dos Alimentos da UFLA, destaca o impacto direto da pesquisa na valorização do produto:
“O uso de leveduras selecionadas permite melhorar o perfil sensorial do chocolate e agregar valor ao cacau, possibilitando que ele seja classificado como cacau fino, e não apenas como commodity.”
Chocolate que nasce na universidade
Além da fermentação, a pesquisa avança para a produção experimental de chocolate em pequena escala dentro da universidade. Equipamentos específicos permitem testar textura, acidez, amargor e cremosidade — tudo com tempo, método e paciência.
O chocolate precisa rodar, descansar e evoluir. Às vezes são 24 horas. Em outros casos, 72 horas. É como café, como vinho: sabor não se apressa.
Para a doutoranda Tarumim Falcão, que também integra o grupo de pesquisa, o objetivo vai além do laboratório:
“A ideia é que Minas Gerais também seja reconhecida pela produção de chocolate de qualidade.”
Formação de pessoas e transformação de territórios
O projeto reúne doutorandos, mestrandos, pós-doutorandos e estudantes de graduação, fortalecendo a formação científica e a pesquisa aplicada.
O estudante Matheus Fernandes, do curso de Biologia da UFLA, ingressou recentemente no grupo e vê no cacau um campo promissor:
“O cacau tem uma história muito rica. Pensar que Minas pode se tornar referência em chocolate de qualidade é algo que anima quem está começando na pesquisa.”
Também atuam no projeto Deyvid Henrique Braga (doutorando em Ciência dos Alimentos), Giovana Ferreira (mestranda em Ciência dos Alimentos) e Luísa Domingos Gomes Paris (Iniciação Científica), cada um contribuindo em diferentes etapas da pesquisa, da microbiologia ao sensorial.
Na retaguarda técnica, a manutenção da coleção de culturas é responsabilidade de Ivani Maria Gervasi, auxiliar técnica de laboratório que atua há mais de 20 anos com a professora Rosane, cuidando da preservação dos micro-organismos que sustentam a pesquisa.
Ciência que aponta para o futuro
A expectativa agora é ampliar ainda mais o diálogo com o campo, fortalecendo a parceria com pesquisadores que atuam diretamente no Norte de Minas. A participação do professor Victor Maia (Unimontes), um dos responsáveis pela consolidação do cultivo de cacau na região, deve trazer esse olhar da produção agrícola, da inovação e do futuro do setor.
Se depender da ciência desenvolvida na UFLA, do apoio institucional da FUNDECC e do financiamento público à pesquisa, o caminho já está traçado — e o chocolate mineiro começa a ganhar identidade, aroma e sabor próprios.

2 respostas para “Quem diria que o Norte de Minas poderia se tornar território do cacau?”
Cássio Luiz de Castro e SilvaParabéns a todos os Stakeholders!
É um grande projeto de inovação.
Pois, entendendo quais microbiotas estão presentes na fermentação do cacau, (através das pesquisas e análises químicas/sensoriais da equipe da UFLA) será possível em um futuro próximo transformar em grande escala, o cacau do Norte de Minas em um chocolate com qualidade e sabor, satisfazendo a sociedade e os clientes.

Deixe um comentário